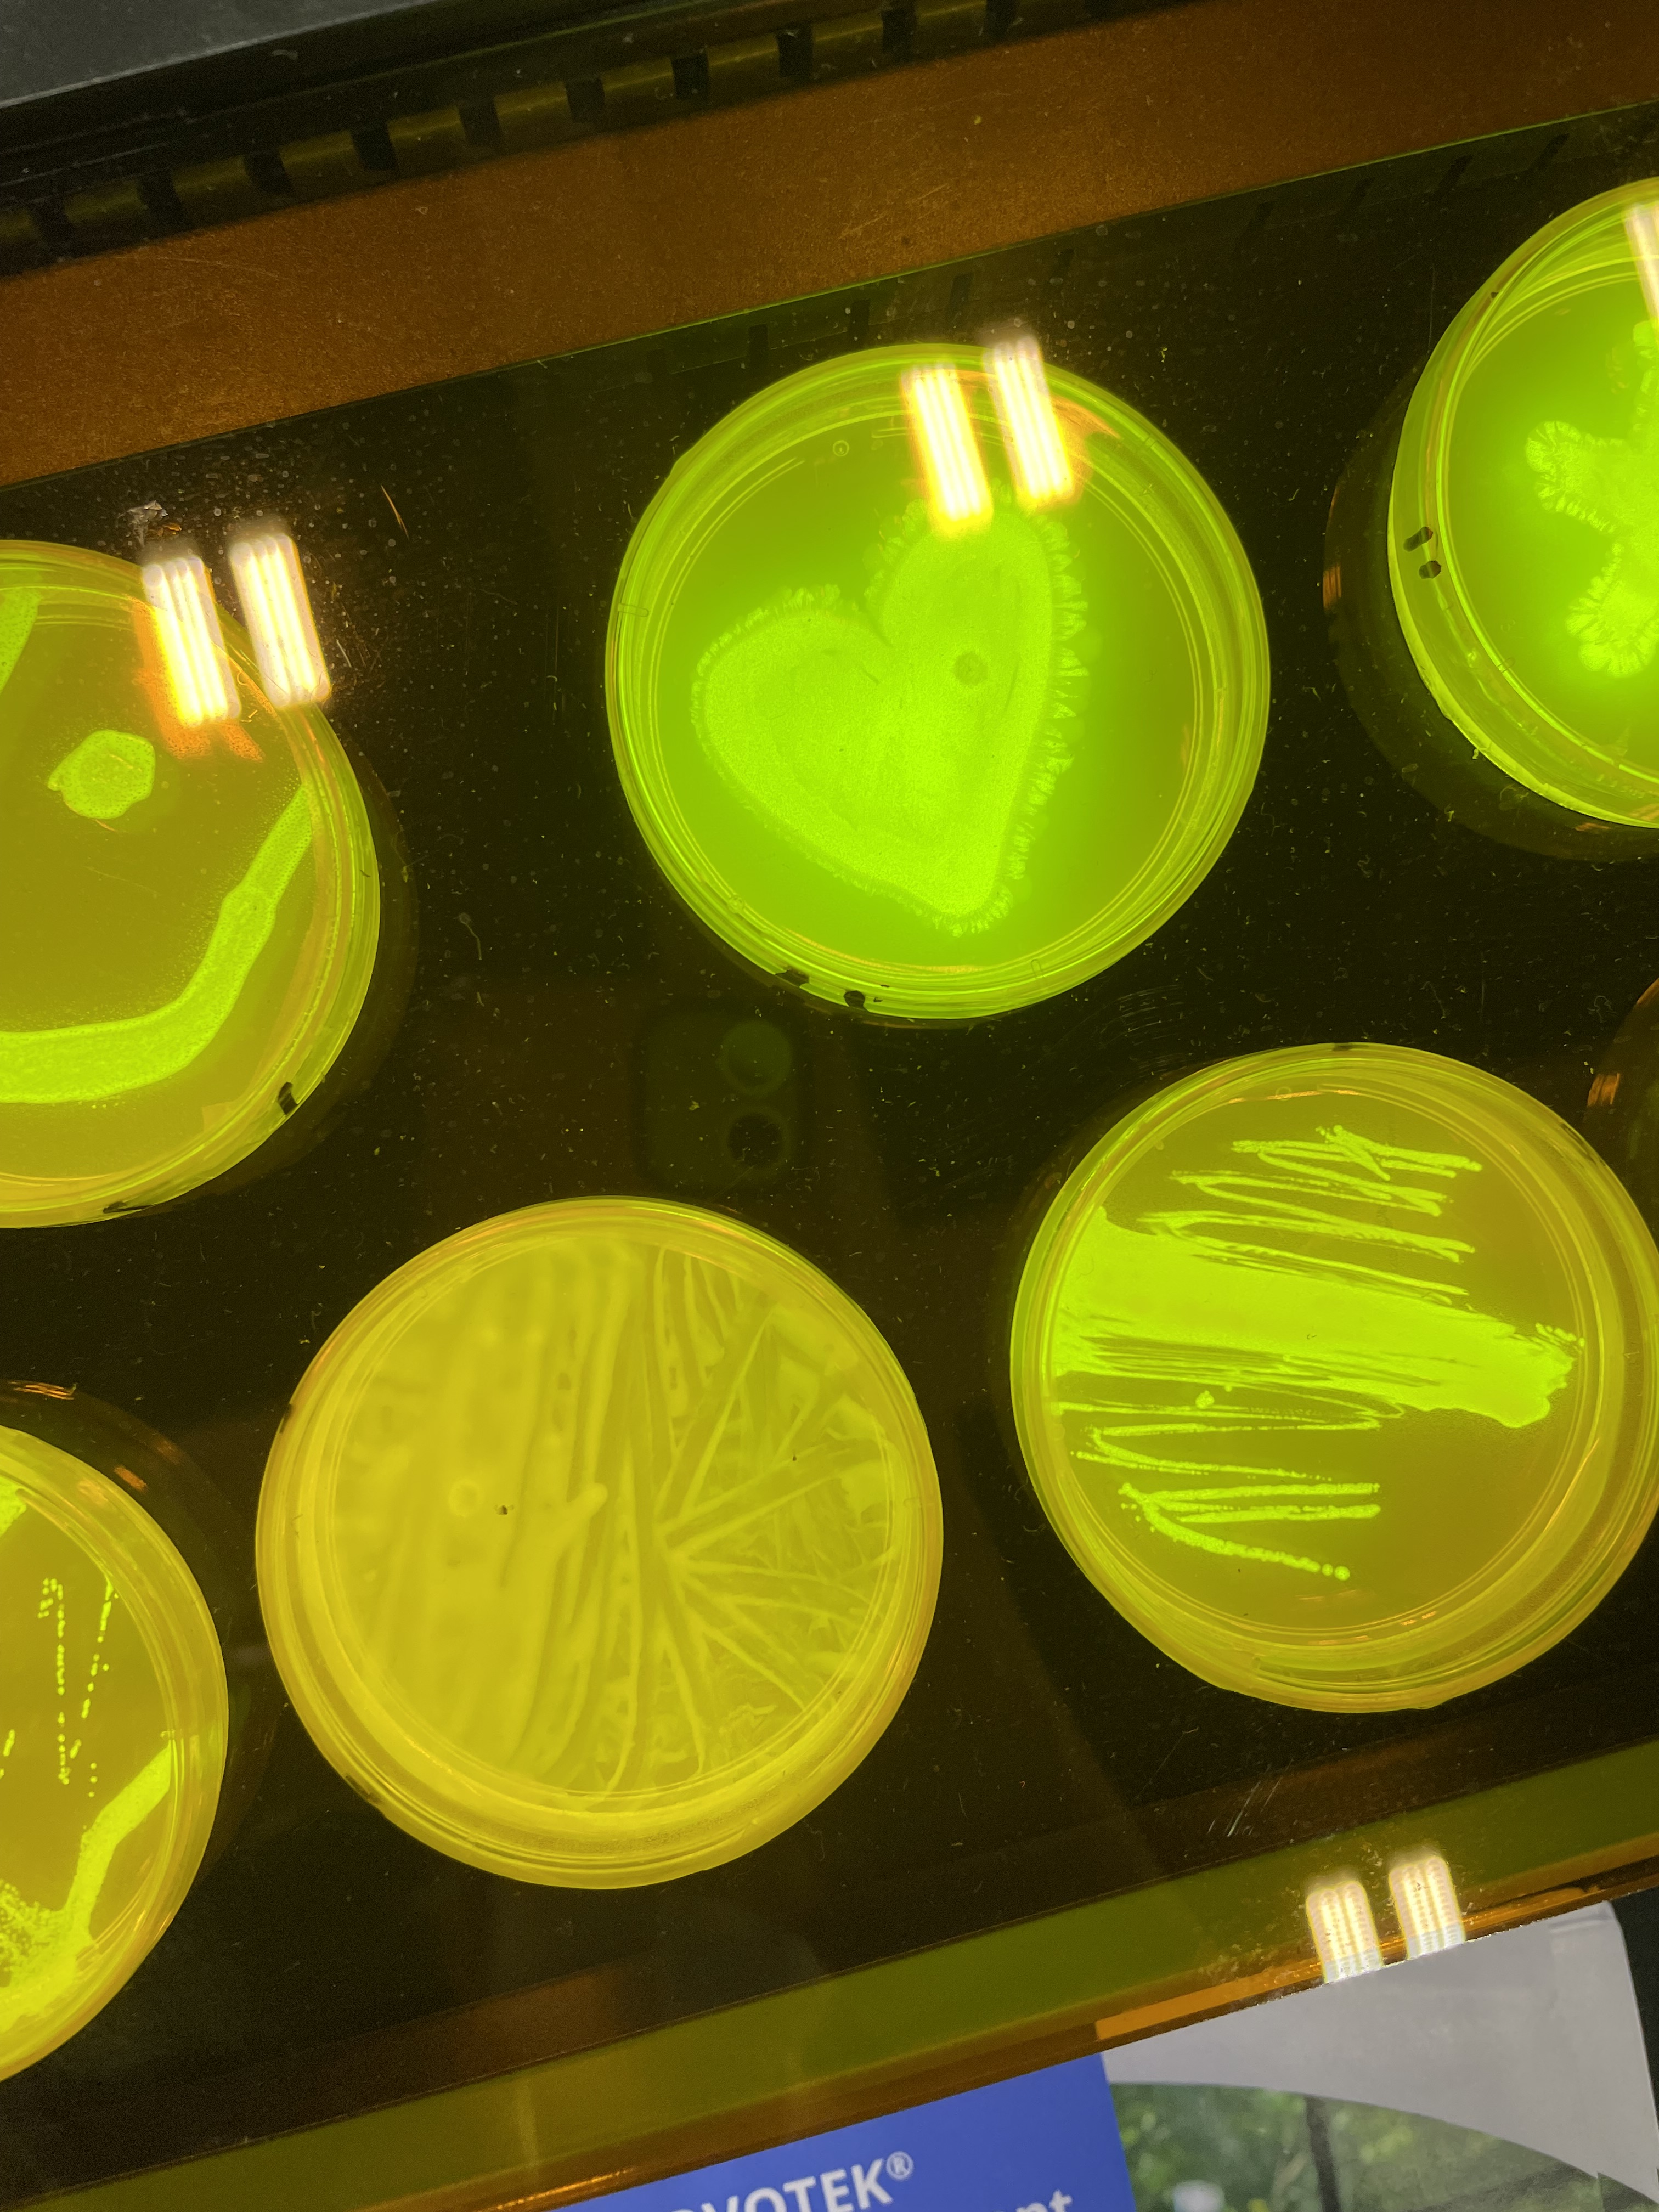

Last week, we kicked off our fall conference schedule with a whirlwind trip to Palm Springs for the CASE (California Association of Science Educators) conference! Our first in-person CASE conference since 2019, we were excited to get back out to California to see old friends and meet new ones. Flying in Thursday morning after barely making our connection through the Phoenix airport, we spent the day setting up our booth, having lunch at Sherman’s, and squeezing in a little pool time to enjoy the beautiful sunny day before our early 7PM bedtime (don’t laugh, we were on East Coast time!).
Friday was off to a fast start with the opening of the Exhibit Hall and our first workshop, “Introduction to Forensics: Left at the Scene of the Crime!“. Saturday was also busy with our 2nd workshop, “Introducing Your Students to Gene Editing with CRISPR.” Many giveaways, including our DuraGels, Biotech A-Z Poster, Dilution Magnets, and temporary DNA tattoos were a huge hit with attendees.
We had a wonderful time and met many engaging educators in our two days at the show. Thank you to everyone who attended one of our workshops or stopped by Booth #204 to say hi!
If you attended one of our workshops and would like to see the digital presentation or workshop literature, they’ve been listed below:
| Workshop | Presentation | Literature |
|---|---|---|
| Introduction to Forensics: Left at the Scene of the Crime | DOWNLOAD | DOWNLOAD |
| Introducing Your Students to Gene Editing with CRISPR | DOWNLOAD | DOWNLOAD |
For our full conference schedule for 2022, please click HERE.